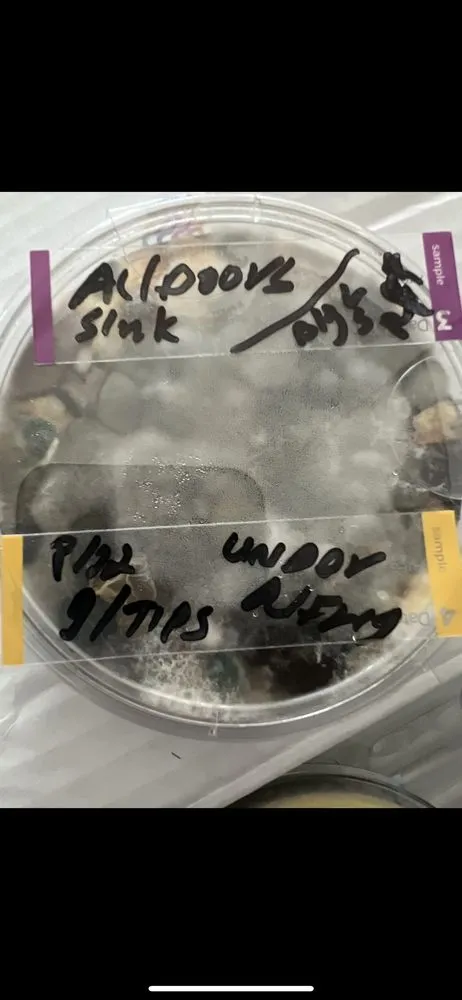
Slide of Hawk Air

FAQs
Why does my large Keller home have hot and cold spots, and how can Hawk Air fix it?
Uneven cooling in spacious homes is often due to an undersized or improperly balanced HVAC system. At Hawk Air, we perform detailed load calculations for Keller homes to recommend and install a correctly sized unit. We also expertly design and adjust ductwork to ensure balanced airflow to every room, eliminating those frustrating hot and cold spots for consistent comfort throughout your home.
Can regular maintenance from Hawk Air prevent a clogged condensate drain and water damage?
Absolutely. A clogged condensate drain is a frequent issue in our Keller climate and a key focus of our maintenance service. During our tune-up, we thoroughly clean the drain line and pan to prevent algae and mold buildup that causes clogs. This simple, proactive step helps avoid water leaks, system shutdowns, and potential humidity or mold issues in your home, saving you from costly repairs.
My AC in Keller isn't cooling evenly—should I repair or replace the system?
It depends on the age, condition, and efficiency of your current system. Our Hawk Air technicians will diagnose the root cause, which could be a repairable issue like a failing component or duct leak. However, if your system is old, inefficient, and consistently struggles to cool your large home evenly, a replacement with a properly sized, modern unit is often the most effective and energy-saving long-term solution for Keller homeowners.
Property Service Solutions
- HVAC system repair
- HVAC installation or replacement
- HVAC system maintenance
Meet the Team
Hawk Air is your trusted local HVAC expert serving Keller, TX. We specialize in solving the common comfort and efficiency challenges faced by homeowners in our community, particularly uneven cooling in large homes and issues caused by clogged condensate drains. Our team provides comprehensive services, from precise system installations designed for balanced airflow to expert repairs and preventative maintenance that keeps drains clear and systems running smoothly. We understand the unique needs of Keller residences and are committed to delivering reliable, long-lasting solutions that ensure your home stays comfortable year-round. Trust Hawk Air for professional, neighborly service that addresses the root of your HVAC problems.
Business Location & Hours
| Mon: | 8:00 AM - 4:00 PM |
| Tue: | 8:00 AM - 4:00 PM |
| Wed: | 8:00 AM - 4:00 PM |
| Thu: | 8:00 AM - 4:00 PM |
| Fri: | 8:00 AM - 4:00 PM |
| Sat: | Closed |
| Sun: | Closed |